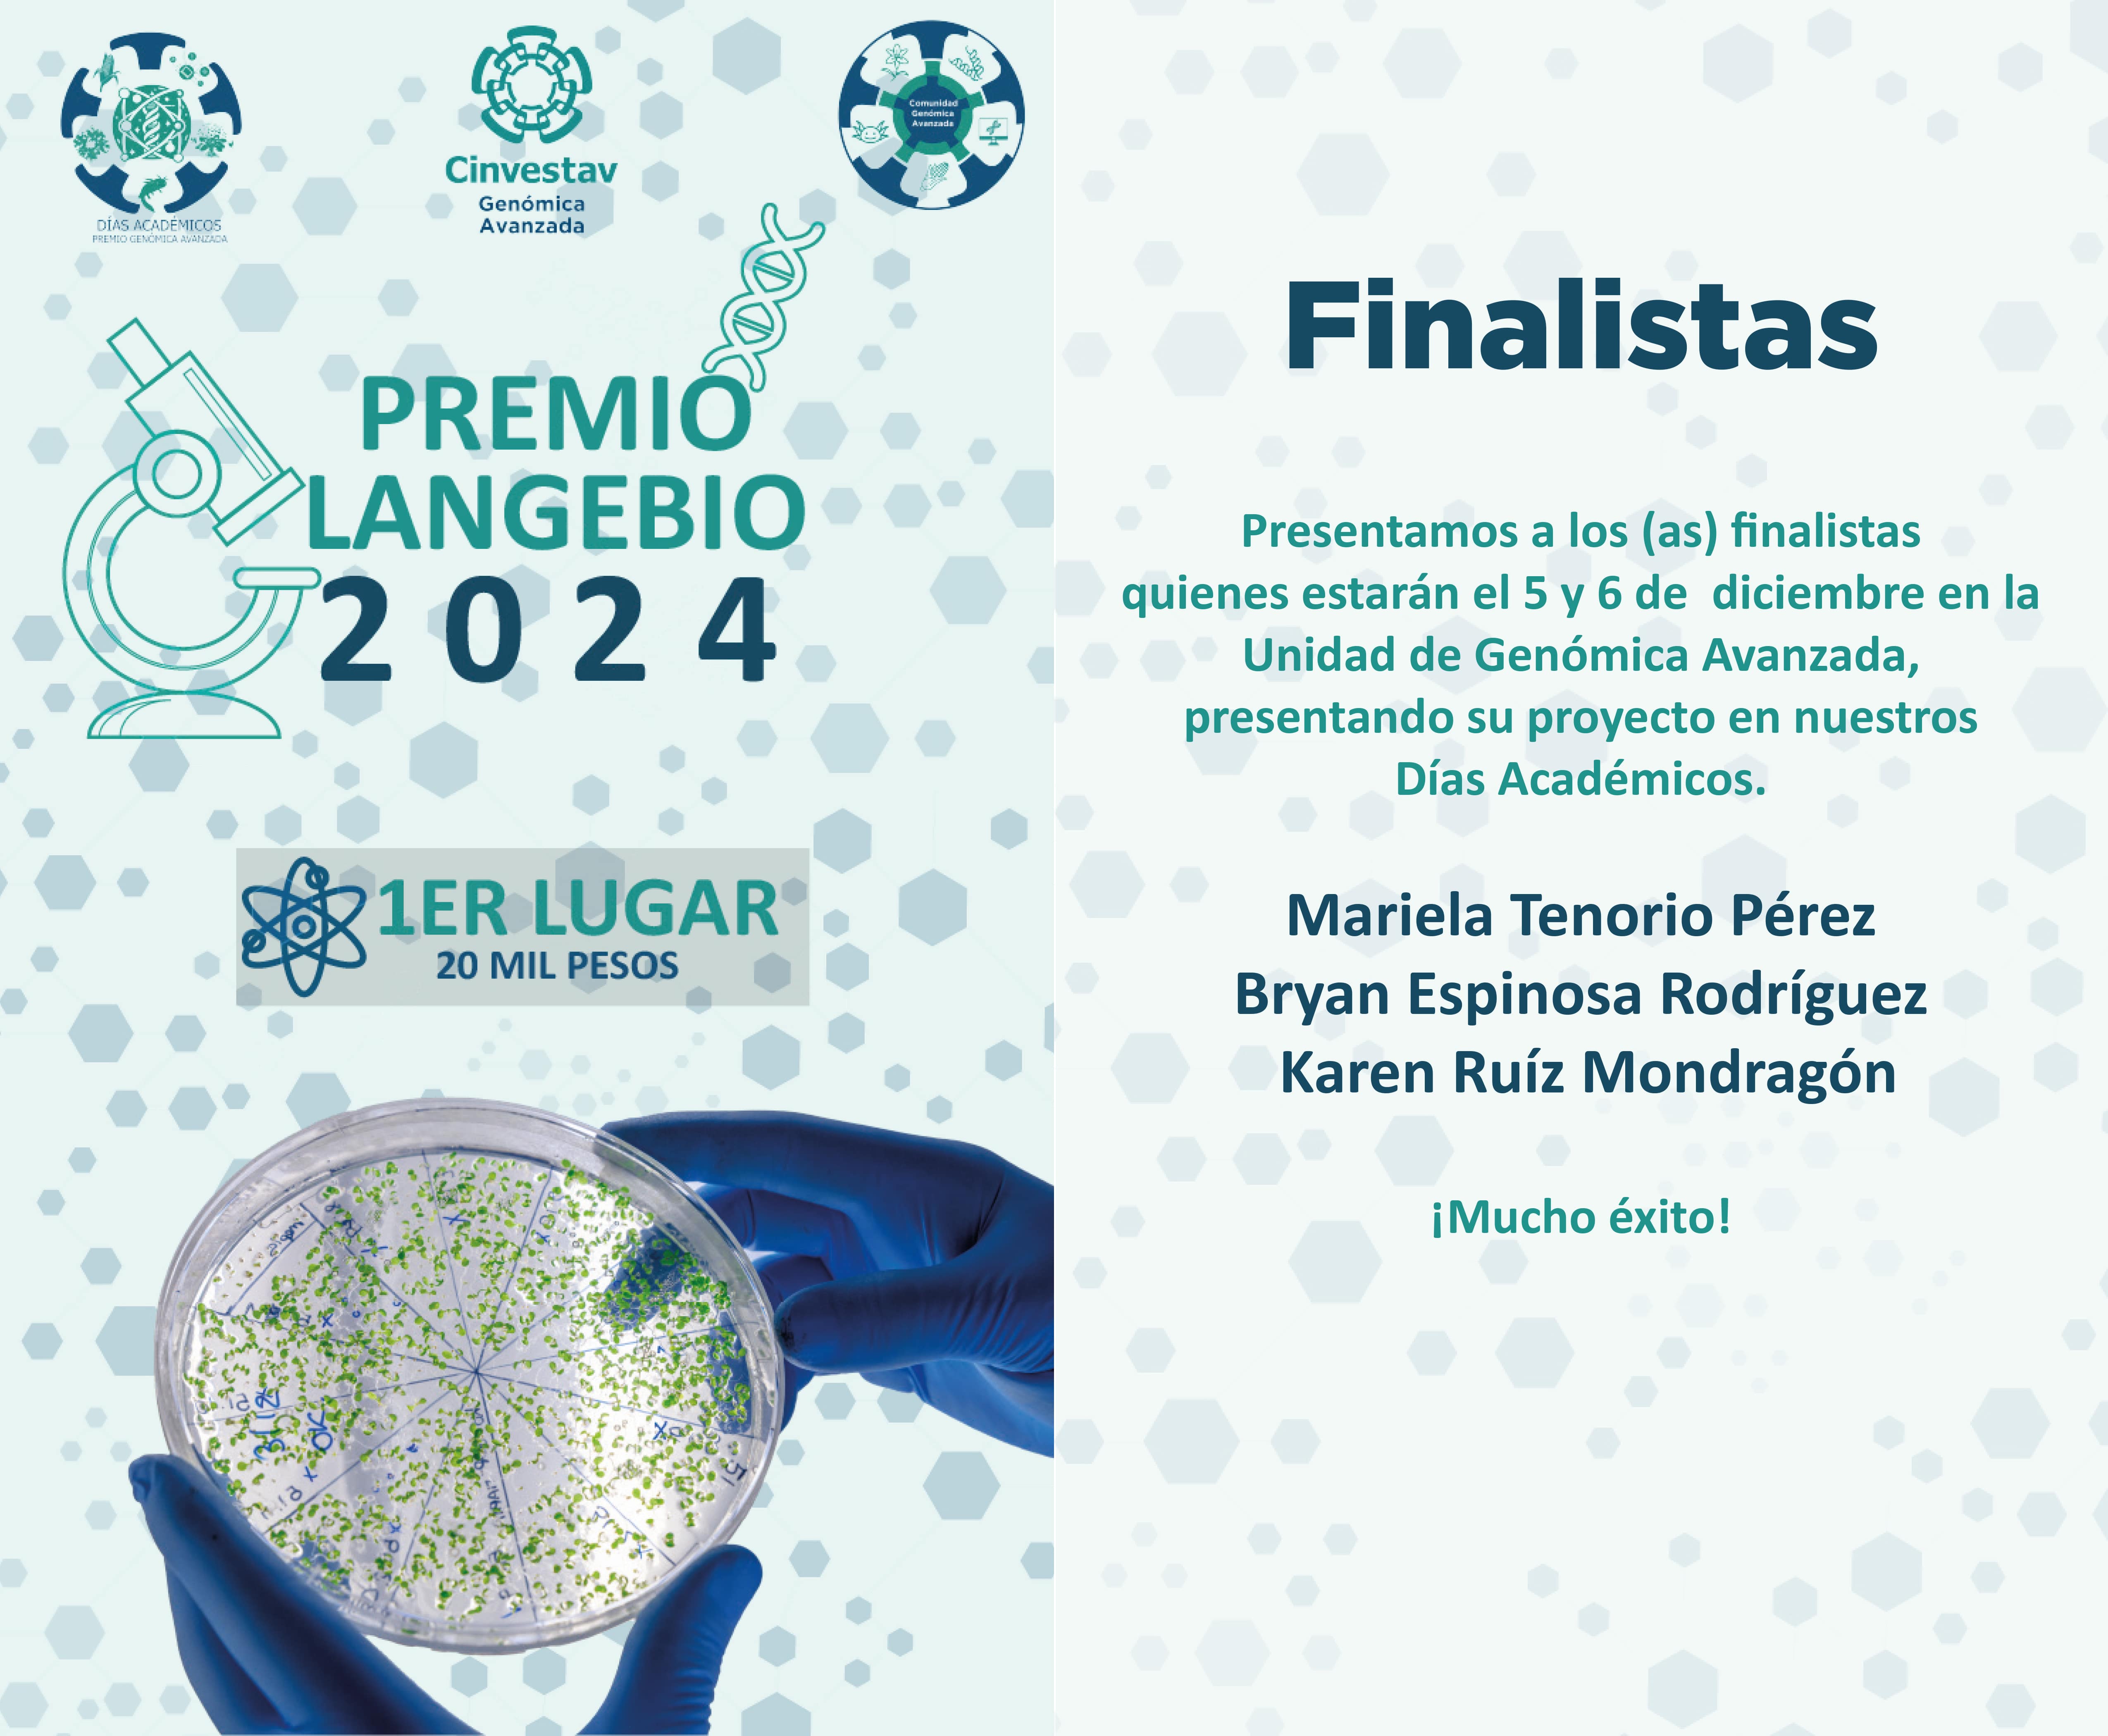

Finalistas Premio Langebio 2024
Días académicos 2024
El jurado ha seleccionado a las y los finalistas que serán invitados a presentar oralmente su trabajo a la ciudad de Irapuato durante el evento "Días Académicos" de Cinvestav UGA.
Agradecemos y felicitamos a todas y todos los participantes ya que la calidad de los trabajos de investigación fue notable.
- Mariela Tenorio Pérez
- Bryan Espinosa Rodríguez
- Karen Ruíz Mondragón
¡Mucho éxito!